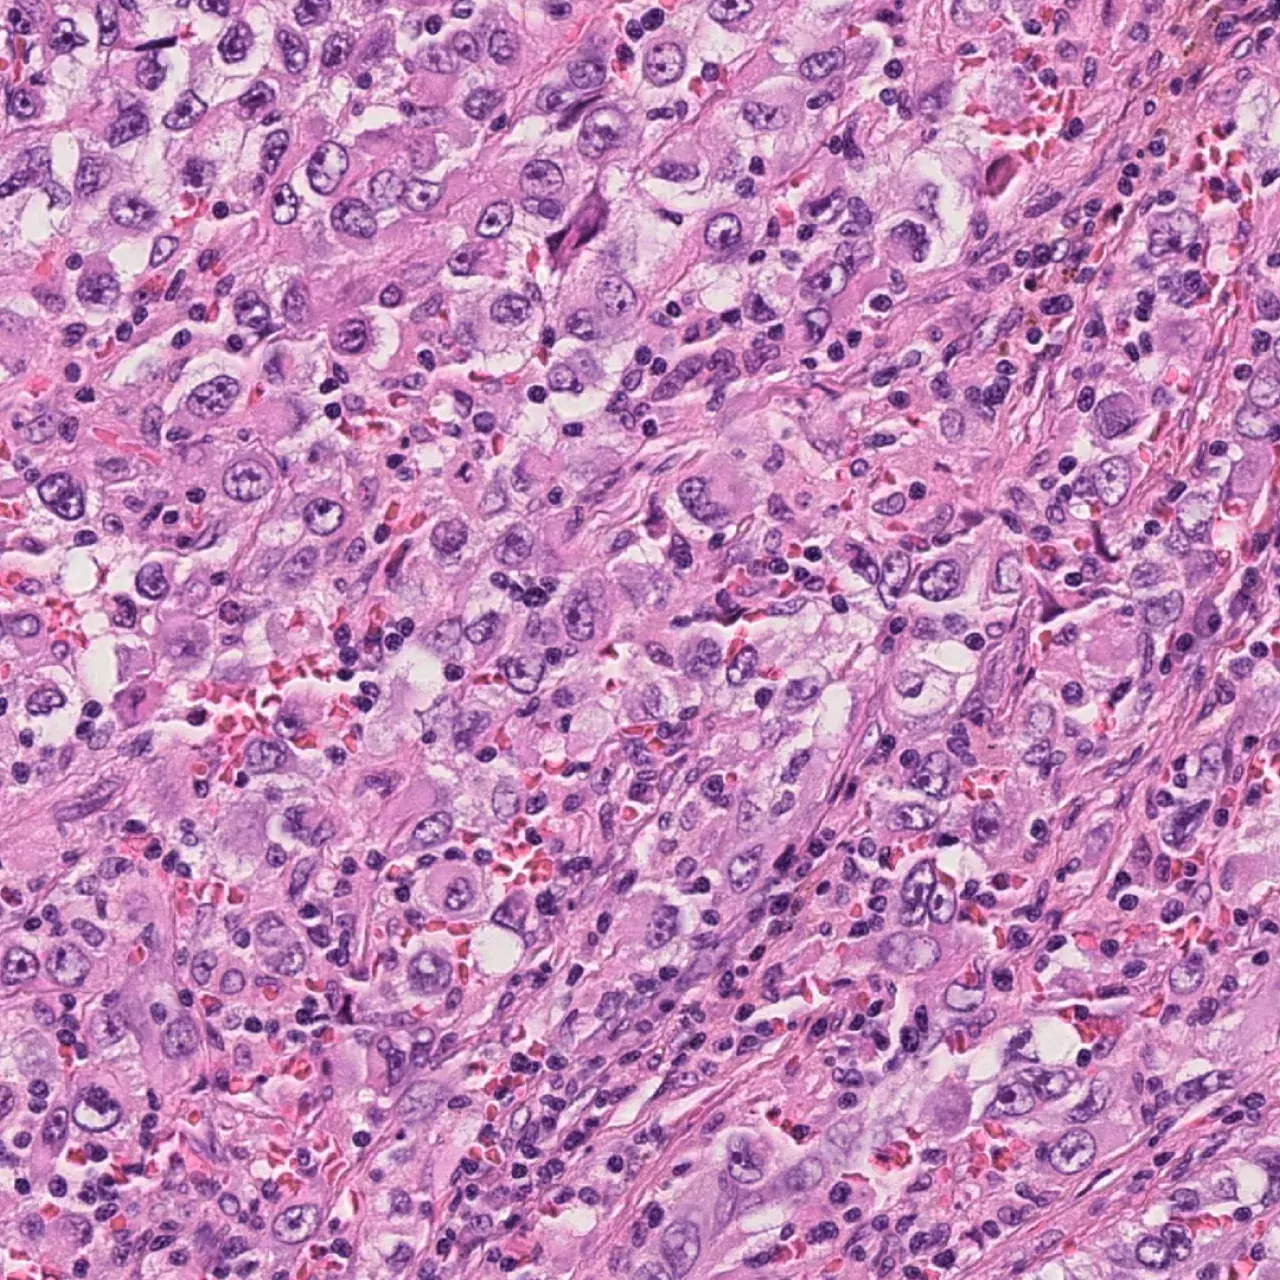
Recherche et Inno

- Accueil
- Chiffres clés 2023
- Projets marquants
Projets marquants
La recherche médicale a fait un bond en avant avec la découverte de la possibilité de diagnostiquer efficacement la maladie d’Alzheimer via des biomarqueurs sanguins amyloïde et tau. Selon un article publié en avril 2023, cette avancée, portée par une équipe internationale menée par les Hôpitaux universitaires de Genève (HUG) et l’Université de Genève (UNIGE), pourrait grandement simplifier le diagnostic et en réduire le coût.
La première greffe de tissu ovarien a été réalisée à Genève auprès d’une patiente prématurément ménopausée des suites d’une chimiothérapie. Cette intervention a été menée par une équipe de spécialistes du pôle FertiGenève, partenariat entre les HUG, la Clinique Générale-Beaulieu et le laboratoire Fertas. Cet acte chirurgical offre un nouvel espoir aux femmes devenues stériles des suites d’un cancer.
L'essor d'un vaccin innovant contre le mélanome, fondé sur la technique de l'ARN messager (ARNm ), pourrait marquer un tournant prometteur dans la lutte contre le cancer de la peau. Avec des résultats préliminaires indiquant une réduction de 65% du risque de récidive et de décès, cette innovation pourrait non seulement transformer le traitement du cancer de la peau, mais aussi ouvrir de nouvelles voies dans le traitement d'autres maladies graves. Les HUG participent à la troisième et dernière phase d’essais cliniques sous la supervision du Pr Olivier Michielin, chef du Département d’oncologie.
Une équipe multidisciplinaire des HUG et de l'UNIGE a traité avec succès un patient souffrant d'une infection bactérienne pulmonaire chronique résistante aux antibiotiques, grâce à l'utilisation innovante de bactériophages, des virus qui s’attaquent aux bactéries. Cette première en Suisse souligne le potentiel de la phagothérapie dans la lutte contre la menace croissante de l'antibiorésistance. Ces résultats ont fait l’objet d’une publication en juin 2023 dans la revue Nature Communications.
Des résultats très prometteurs dans le domaine de l’immunothérapie ont été réalisés par une équipe de recherche suisse, combinant les efforts de l'UNIGE, de l’Université de Lausanne (UNIL), des HUG et du CHUV. Publiée dans la revue Nature en septembre 2023, cette étude démontre comment renforcer les cellules immunitaires artificielles CAR-T, ouvrant de nouvelles perspectives dans le traitement du cancer.